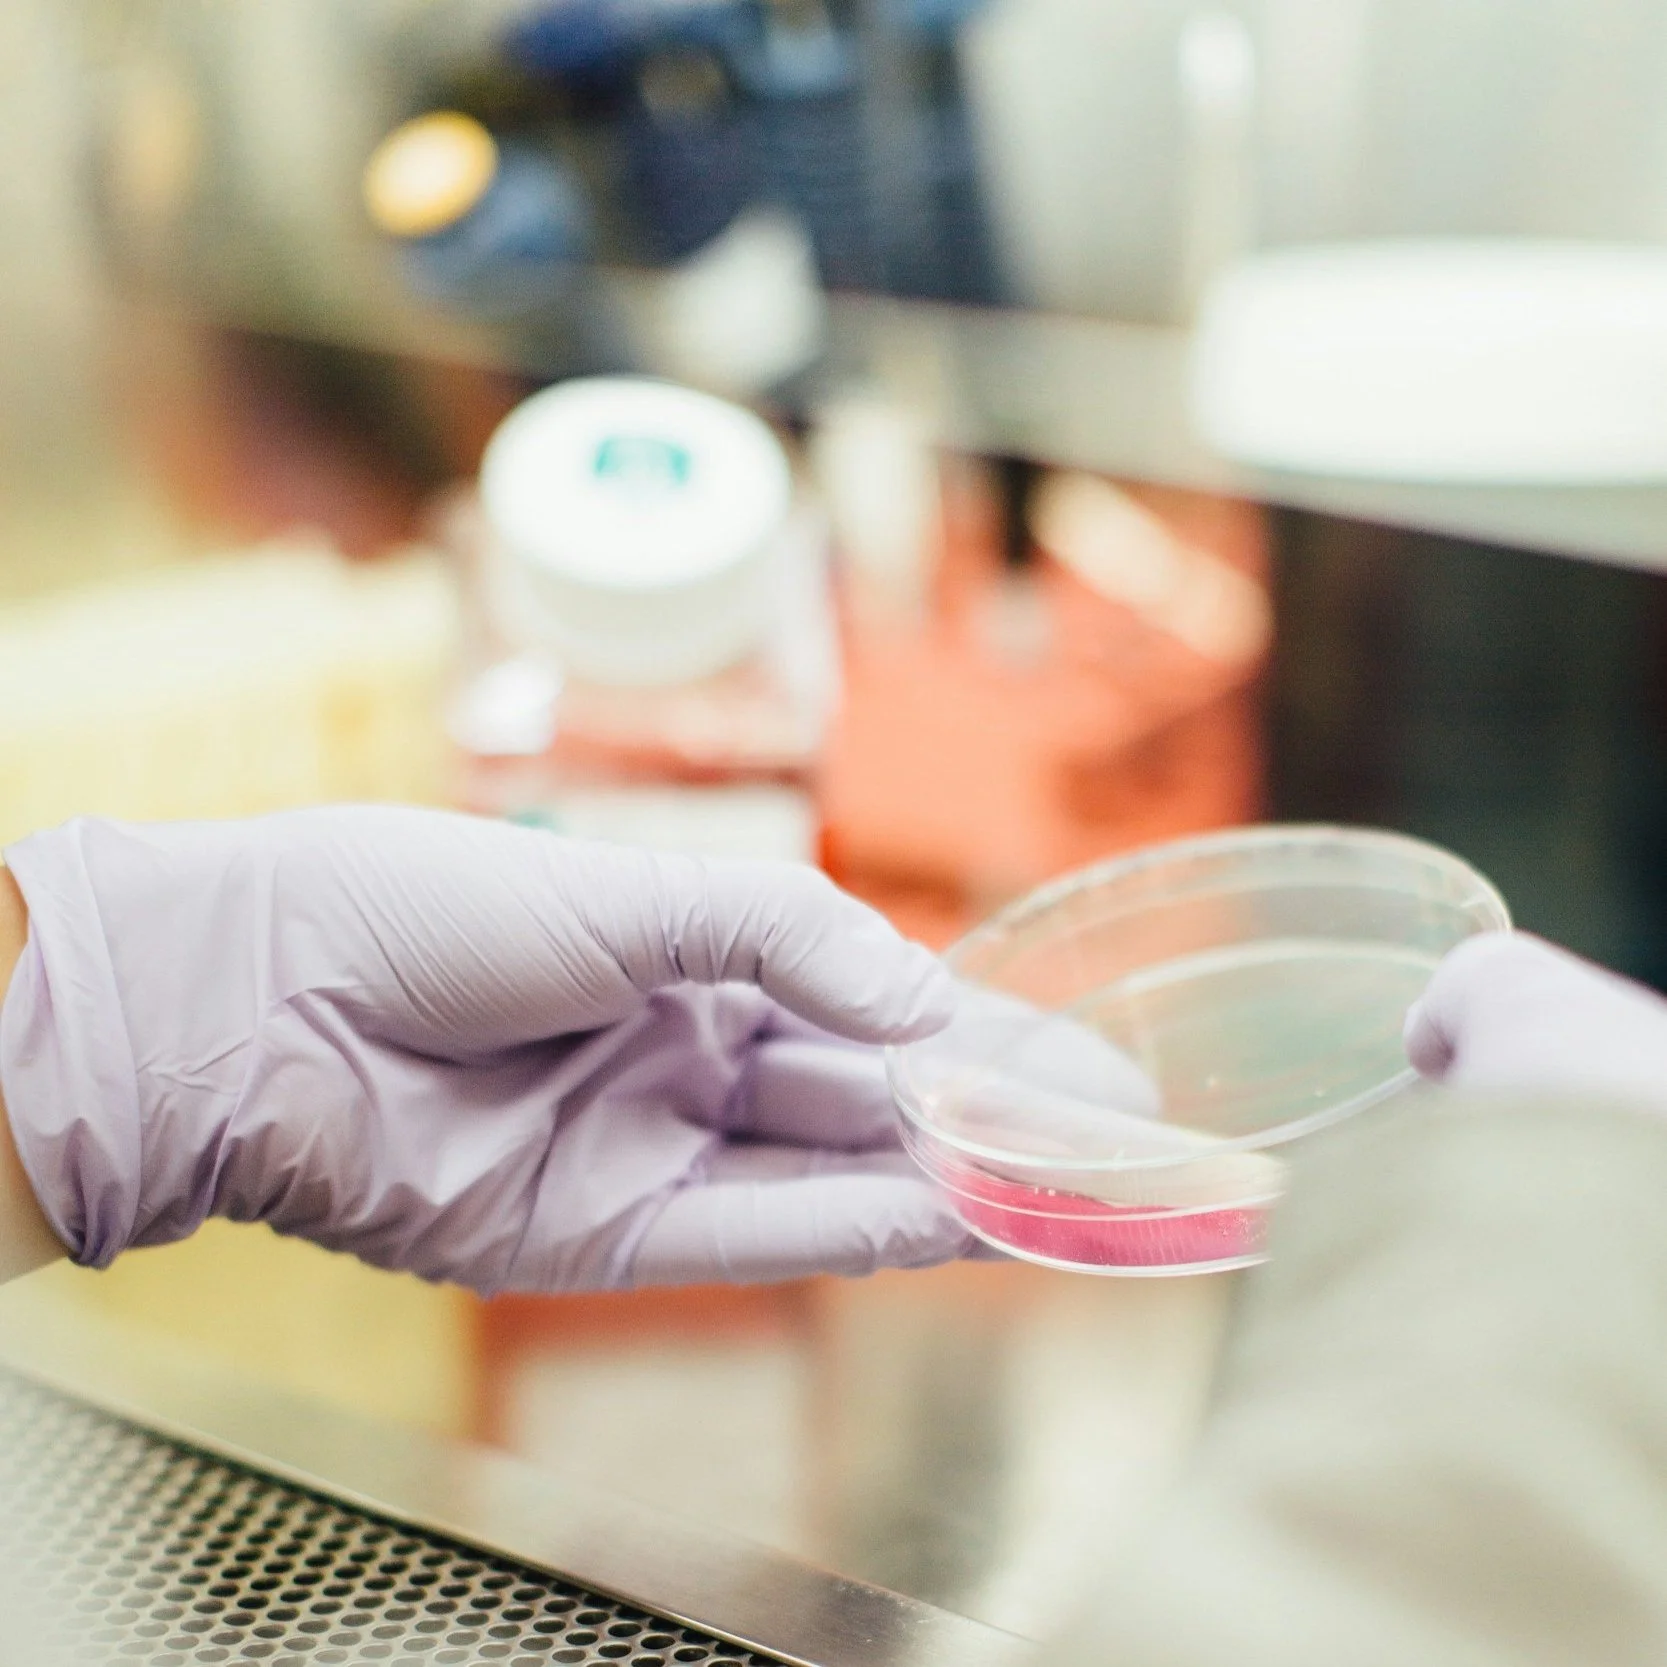

SPIRE
provides a range of psychometric services to ensure the defensibility of our client’s exam programs and offer defensible innovative alternative solutions to traditionally costly and time consuming processes. We are also pretty awesome to work with (so we are told).
OUR SERVICES
PROJECTS
-
Designing, developing, and implementing a technical entry to practice examination is no small task but likely Spire is here to guide our clients through the process. We are experts in not only the technical design of entry to practice exams but also in development of the exam program through all of the psychometric processes from competency profile development to blueprinting to item development to exam delivery. In addition we guide our clients through the policies and financial options that future-proof high-stakes exam programs to be self-sufficient and well funded.
-
SPIRE has extensive experience with the design, development, and implementation of jurisprudence examinations in virtually every professional industry. This experience allows us to offer clients a cost effective rapid approach to jurisprudence exam development without sacrificing defensibility.
-
Practice tests are an invaluable resource to candidates preparing to take their exam. In addition, practice tests can generate supplementary funds for regulators and exam providers. Spire is able to leverage our knowledge and expertise to offer clients efficient approaches to develop the surplus items required to not only populate a practice test program but set it up online to collect fees and allow candidates to access the practice tests 24/7/365 from anywhere in the world.
-
Ensuring that your exam program meets international recognized standards in the assessment industry is top of mind for our clients. Spire offers defensibility audits which compare a clients exam program with internationally recognized standards for high-stakes assessment identifying strengths and weaknesses with recommendations. Our clients value our hands-on approach which provides more than a generic report that is of limited use. Spire ensures that our clients are provided with a path forward to address defensibility gaps in their exam program and enhance the organization’s defensibility strengths.
-
Transitioning from paper-based exams to computer-based exams offer many benefits including enhanced security, remote proctoring options, and faster turnaround of results to name a few. At Spire we have over 45 years of combined experience helping organizations move their paper-based exams to online modern, secure, reliable item authoring, banking, and exam administration platforms.
-
Assessing practical knowledge, skills and abilities is a fundamental need of regulators and there are many options to approach assessment of these areas such as an OSCE. Spire has extensive experience designing, building and implementing clinical exams, practical exams, and OSCE and performance based examinations including scale development, scoring models, and standard setting approaches.
-
SPIRE has conducted numerous special studies for organizations ranging in topics from approaches to standard setting with small sample sizes, proposing methodologies to evaluate the defensibility of using third party exams (e.g., US certification/licensing exams), to evaluating the entry to practice requirements for applicants (Canadian and internationally educated) and the assessment approaches that best support the assessment of candidate competence.
PROCESSES
-
At SPIRE we support our clients through all areas of their exam program. Competency profile/Job Task Analysis (JTA) is the process of establishing industry relevant competencies at a specific level of proficiency required for successful performance in a field. Generally competency profile/JTA development is a multi-step process involving interviews, surveys, focus groups and so on, all of which Spire can guide an organization through to best support the foundations of a client’s exam program.
-
A high-quality examination blueprint is a recipe for the assembly of a defensible exam. Multiple-choice exams to OSCEs, live or remote sessions, Spire will design and conduct processes to create blueprints to fit your circumstances and needs.
-
The development of test questions and tasks (e.g., OSCE - Observed Structured Clinical Examinations) is the single-most time and resource-intensive activity that testing organizations will conduct. Spire staff has deep experience in the fundamentals of a successful item or task. Spire offers innovative AI Assisted Item Development approaches that dramatically increases the number of items that can be developed in a far shorter period of time at less cost than traditional item development.
-
The assembly of a defensible exam requires many constraints to be satisfied beyond the blueprint. For a licensing exam, constraints for cognitive level, gender, passages, images, specific competencies, average difficulty, discrimination, and common items are typical. Spire uses optimization technology for assembly so you can administer an exam with the precise characteristics you require and one that’s fair to your test takers.
-
Item analysis is the critical step where your organization gains insight into how your candidates are understanding your items. Classical or Item Response Theory, Spire will provide not only the key statistics but also a concrete interpretation of the numbers so you can have clarity about how your items are functioning and what specific changes could make them better.
-
The function of a certification or licensing exam is to make sound decisions about the capabilities of test takers. These decisions have profound effects as they determine whether the public is protected when they engage the services of a professional and also if the candidate is able to earn a living in the occupation they’ve trained for. Standard setting sets the threshold for determining the readiness of candidates for professional practice and is one of the key services offered by Spire. From modified Angoff to Nedelsky, Borderline regression to Bookmark, we can facilitate a session that best fits your program.
-
In testing, accuracy and interpretability go hand in hand. Though accurate numbers reveal the capabilities of candidates, well-designed reports allow those numbers to make sense to people. Spire takes care of both. Response data are always double-scored and matched to ensure 100% accuracy; carefully crafted reports reveal the desired interpretations and discourage inappropriate ones.
-
Unfortunately cheating on tests and content theft is a reality that all organizations that administer assessments need to prevent and address in order to ensure the validity of their exam programs. Spire are experts in collusion detection (assessing whether candidates are copying/sharing item answers with one another) and whether test security issues are present. We don’t just do the analyses and throw the analyses over the fence to our clients to deal with, we support our clients completely, walking them through the detected collusion/test security issues and recommending appropriate courses of action.
PROFESSIONS WE HAVE SERVED


Dental Technologists
Dental Hygienists


Dentists
X-ray Technologists

Medical Laboratory Scientists
Lawyers

Engineers
Geoscientists


Physiotherapists
Massage Therapists




Paramedics
Agrologists


Opticians
Optometrists


Pharmacists
Veterinarians


Nurses
Midwives


Respiratory Therapists
Insurance
Acupuncture & Traditional Chinese Medicine
Audiologists & Speech Language Pathologists


Financial Planners
Accountants